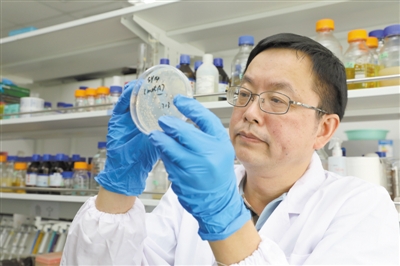
星天地

语音播报
覃重军在观察单染色体酵母的生长情况。杨正行摄
“照亮我前进道路并不断给我勇气去正视失败的,是对科学的热爱,对揭示生命世界奥秘的向往以及科学发现给我带来的纯真快乐……”
“只有像我这样的‘外行’才敢去做,成千上万和真核模式生物酿酒酵母打交道的科学家一定被这个大胆的想法吓坏了。”今年53岁的覃重军在转述他人的玩笑话时,脸上露出了顽皮的笑容。
在很多研究酵母的专业人士眼里,星天地娱乐城官网 分子植物科学卓越创新中心/植物生理生态研究所研究员覃重军无疑是个“外行”。
覃重军曾在原核链霉菌领域深耕了30年。在2013年之前,比起酿酒酵母,他的科研工作更多与链霉菌、大肠杆菌等原核生物相关。
但就是这个从未研究过真核生物的“外行”,用整整5年时间进行了一次奇幻冒险:用基因编辑的方法,将酿酒酵母中16条天然染色体合成为1条,创建出了国际首例人造单染色体真核细胞,实现“人造生命”里程碑式的重大突破。该成果于8月2日在线发表在《自然》杂志上。
“打破真核生物与原核生物间的‘隔阂’,把复杂生命变简单。”这是覃重军开启“16合1”冒险之旅的初心。
置之死地,挥别过往开启冒险之旅
2013年,对覃重军来说,是“置之死地”的一年。
那年5月8日,覃重军下决心进行一次大冒险,将目光瞄准了真核单细胞生物的模式材料——酿酒酵母。在此之前,覃重军在自己的研究领域早已硕果累累。在学术上,他带领团队首次在粘细菌中发现质粒并建立遗传操作系统,全世界有20多个实验室来函索取质粒载体;同时他们对大肠杆菌的基因组进行了“删减、重组、优化、合成”等操作,做了大量有益的探索。在产业化上,他的团队与国内制药企业合作改良了抗寄生虫药物多拉菌素,打破了国外在该领域的垄断,药品销售额超过亿元。
一位科学家放弃原来的研究内容,转而开拓其他领域,这其中的难度不言而喻,而覃重军偏要试一把。
告别过往荣光、重新开始,并不是他的心血来潮。他觉得,当时他和团队正在研究的大肠杆菌基因组技术框架是由国外科学家提出来的,很难再有新的突破。这对覃重军来说,是难以忍受的。
如何突围?他决定把研究对象从原核生物大肠杆菌换成真核生物酿酒酵母,“因为人类就是真核生物,和人靠得越近,研究意义越大”。
自然界存在的生命体可分为真核生物和原核生物。真核生物细胞含有多条染色体,而且都呈线型结构,比如人类、小鼠、酿酒酵母等都是真核生物。原核生物细胞通常只含有1条染色体,而且是环型结构,比如大肠杆菌、破伤风菌等。
真核生物能否像原核生物一样,用1条染色体来装载所有遗传物质?
“这是个只有外行才敢有的念头,一开始没有多少人觉得我能做出来,要走别人没走过的路就需要冒险。”覃重军说。
前途未卜,从科学伟人身上汲取力量
在覃重军的办公桌上,堆着厚厚一摞、近2000页的A4纸。2013年至今近5年的时间里,他对于这一课题的思索、设计、修改都记在上面。纸上密密麻麻写满了字,有的还用红笔标记出修改之处,每一页内容都见证了过程的曲折。
这条路没有人走过,更没有可以借鉴的样本,唯一能伴覃重军前行的是对未知的好奇心。早在研究原核生物大肠杆菌时,他就曾写过这样一段话:“一个散步者的遐想:我叫大肠杆菌,如果可以被自上而下或自下而上地重构、模块化、简约化……甚至可以与其他生物形成杂合生命体——那我还叫大肠杆菌吗?”
原来“天马行空”的种子,早已在他心里发芽。
大胆猜想之后,更需要小心求证——他和团队确定原则、精细设计、预备试验、工程化高效而精准地实施。
覃重军研究组随机从酿酒酵母16条染色体中任意选了2条进行了融合。如此操作了8次,他们惊奇地发现——菌株的生长速率几乎没有发生变化。这意味着,虽然染色体数量减少,但酵母菌仍能顺利存活、繁殖,生存能力几乎未受影响。也就是说,原先的大胆猜想是有可能实现的。
在此基础上,覃重军与同事设计了人造酵母染色体的实验总体方案。覃重军的博士生邵洋洋从2013年开始尝试并使用高效的染色体操作方法,历经4年,通过15轮染色体融合,最终成功得到只有1条线型染色体的单细胞真核生物酿酒酵母菌株SY14。
做实验的那段日子,他重温了最爱的《爱因斯坦文集》《达尔文回忆录》《巴斯德传》,并在书上划出令他“心有戚戚焉”的句子。与巴斯德、达尔文、爱因斯坦、牛顿等科学家对话,常能给“置之死地”的覃重军“醍醐灌顶”的感觉。
面对质疑,用实验数据回击“百般刁难”
对覃重军来说,维持研究团队的运转经费一直是件让他感到头疼的事。
多年来,覃重军研究组的“赤字”数额超过300万元。“我是所里最有名的经费‘负’翁,而且整整五年,我没有发表一篇与酵母相关的论文,换在别的单位,或许早就让卷铺盖走人了。”回想起这些年的艰苦经历,他淡然一笑地说。
困难,自始至终都存在。论文投稿后,审稿人“百般刁难”。他们根本不相信中国科学家能将16条染色体合成为1条,比覃重军团队早两个月投稿的美国科学家杰夫·博克团队只能将16条染色体合成为2条,穷尽努力也没能“合二为一”。杰夫·博克团队和哈佛大学等权威审稿人最初甚至认为,从理论上推论两条是最佳,也是唯一的选择。因此,审稿人要求覃重军研究组完整重复几乎所有的实验,并补充大量的额外实验。
面对困境,覃重军选择迎难而上,“与时间赛跑”。覃重军说,研究组成员和合作者耐心地重复了整个实验,并进一步提升了实验效率,整个实验周期从6个月缩减到3个月,未来有望进一步缩短。
覃重军曾在他的博士论文的后记中写道:“在近1300页的实验记录中,失败何止百次!然而,没有一次失败能够真正打垮我,为什么?照亮我前进道路并不断给我勇气去正视失败的,是对科学的热爱,对揭示生命世界奥秘的向往以及科学发现给我带来的纯真快乐……对我而言,科学是一条无穷无尽的探索之路,也许一生都会这样干下去。”
不忘初心。年轻时的科学梦想,在20多年后的今天还在驱动覃重军继续他的探索之路。
人物档案
覃重军,生于1965年2月,籍贯湖南省邵阳市,现任中科院分子植物科学卓越创新中心/植物生理生态研究所研究员、中科院合成生物学重点实验室主任,主要研究领域为合成微生物学与生物制造。
(原载于《科技日报》 2018-08-20 05版)
© 1996 - 星天地-星天地娱乐城官网 版权所有
京ICP备05002857号-1
京公网安备110402500047号 网站标识码bm48000002
地址:北京市西城区三里河路52号 邮编:100864
电话: 86 10 68597114(总机) 86 10 68597289(总值班室)
© 1996 - 星天地-星天地娱乐城官网 版权所有
京ICP备05002857号-1
京公网安备110402500047号 网站标识码bm48000002
地址:北京市西城区三里河路52号 邮编:100864
电话: 86 10 68597114(总机) 86 10 68597289(总值班室)
© 1996 - 星天地-星天地娱乐城官网 版权所有
京ICP备05002857号-1
京公网安备110402500047号
网站标识码bm48000002
地址:北京市西城区三里河路52号 邮编:100864
电话:86 10 68597114(总机)
86 10 68597289(总值班室)